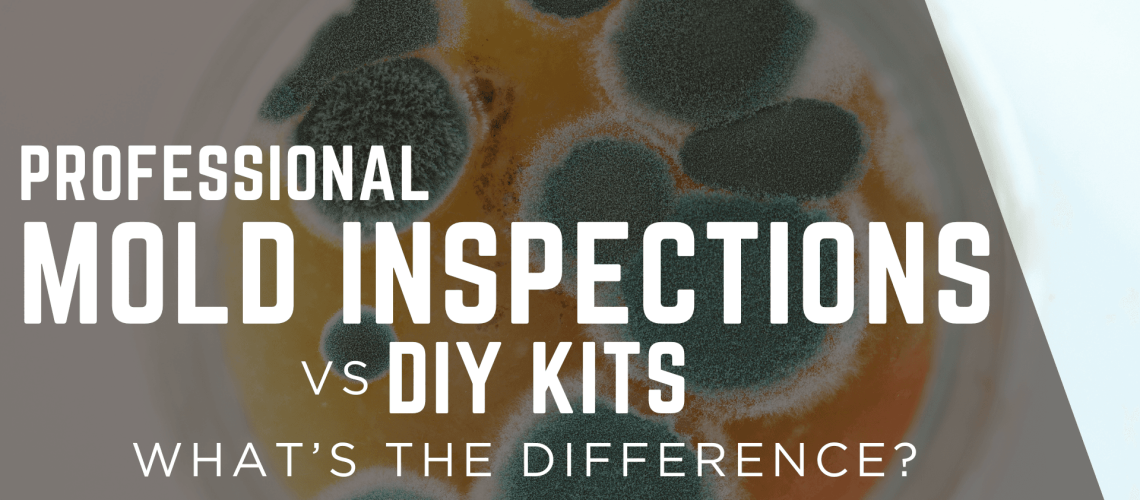
professionalmoldinspectionsvsdiykits professionalmoldinspectionsvsdiykits

If you walk through any big-box hardware store in Memphis, you’ll find plenty of inexpensive mold test kits promising quick answers. For around $40, they claim to tell you if you have mold — but what they don’t tell you is how limited those results really are.
As a certified home and mold inspector, I’ve tested hundreds of homes across West Tennessee, and I can say with confidence that while DIY kits can seem convenient, they rarely provide the full picture. When it comes to protecting your home and your health, there’s a big difference between a petri dish on a countertop and a certified mold inspection backed by lab results and professional interpretation.
The Problem with DIY Mold Kits
DIY mold kits sound appealing because they’re easy — you just open the test plate, let it sit out, and send it to a lab (sometimes). But here’s the truth:
- Every home has mold spores. They’re part of the natural environment, and the presence of spores doesn’t automatically mean you have a problem.
- DIY kits can’t tell you how much mold is in the air, what type it is, or where it’s coming from.
- Most kits aren’t controlled for air volume or time, meaning results can’t be compared to any standard or reference level.
The result? Many homeowners either panic over harmless background spores or assume everything is fine when hidden growth is still active behind walls or under flooring.
What a Professional Mold Inspection Includes
When I perform a professional mold inspection through Upchurch Inspection, it’s a complete diagnostic process — not just a single sample. It starts with a full visual assessment and moisture evaluation of the home, identifying likely sources of leaks or humidity.
Then, I use air sampling and surface testing with calibrated pumps that pull a measured volume of air through collection cassettes. This allows for a true indoor-to-outdoor comparison — a crucial step that DIY kits can’t replicate.
Samples are sent to an accredited environmental laboratory, where specialists identify the types and concentrations of spores present. The final report provides real data, not guesswork, along with professional interpretation and recommendations for moisture control or remediation.
Why Accurate Results Matter
Knowing whether you have mold isn’t enough — you need to know what kind, how much, and why. Professional testing identifies harmful species such as Stachybotrys, Chaetomium, and Aspergillus/Penicillium, which are common in West Tennessee crawlspaces and attics.
Understanding those levels can make the difference between a simple cleaning project and a full-scale remediation plan. It can also help homeowners prove to builders, insurance companies, or tenants that a problem exists — something DIY kits can’t do reliably.
The Local Factor: Memphis Humidity and Hidden Moisture
In the Memphis area, humidity and condensation are constant challenges. Crawlspaces and older HVAC systems create conditions that promote hidden moisture — and mold thrives where air doesn’t circulate.
That’s why professional inspections often reveal problems that would never show up on a DIY plate. Airborne spore levels can spike when a leak forms, a duct disconnects, or insulation becomes damp — all issues a trained eye can identify during the inspection.
When to Consider Mold Testing
You don’t need visible mold to justify testing. Schedule a professional inspection if you notice:
- Persistent musty or earthy odors
- Recent or past water leaks
- Allergy-like symptoms that worsen indoors
- Staining or discoloration on walls or ceilings
- Unexplained moisture around baseboards, windows, or HVAC vents
If you’re buying a home, mold testing can also be added to your home inspection package to ensure hidden moisture isn’t waiting behind the drywall.
Trust a Certified Inspector, Not a Plastic Plate
A mold test should give you more than a yes-or-no answer — it should help you understand your home’s overall condition. Professional testing does exactly that.
At Upchurch Inspection, I provide unbiased, lab-certified mold testing across Memphis, Bartlett, Germantown, Collierville, Arlington, and Lakeland. Each inspection includes real data, photos, and actionable steps so you can make informed decisions about your property.
📞 Schedule Professional Mold Testing in the Memphis Area
Don’t rely on guesswork. Whether you’re buying a home or protecting your current one, Upchurch Inspection provides certified mold testing that identifies hidden problems and gives you peace of mind.
📞 Call (901) 350-8885 or visit UpchurchInspection.com to schedule your mold test today.